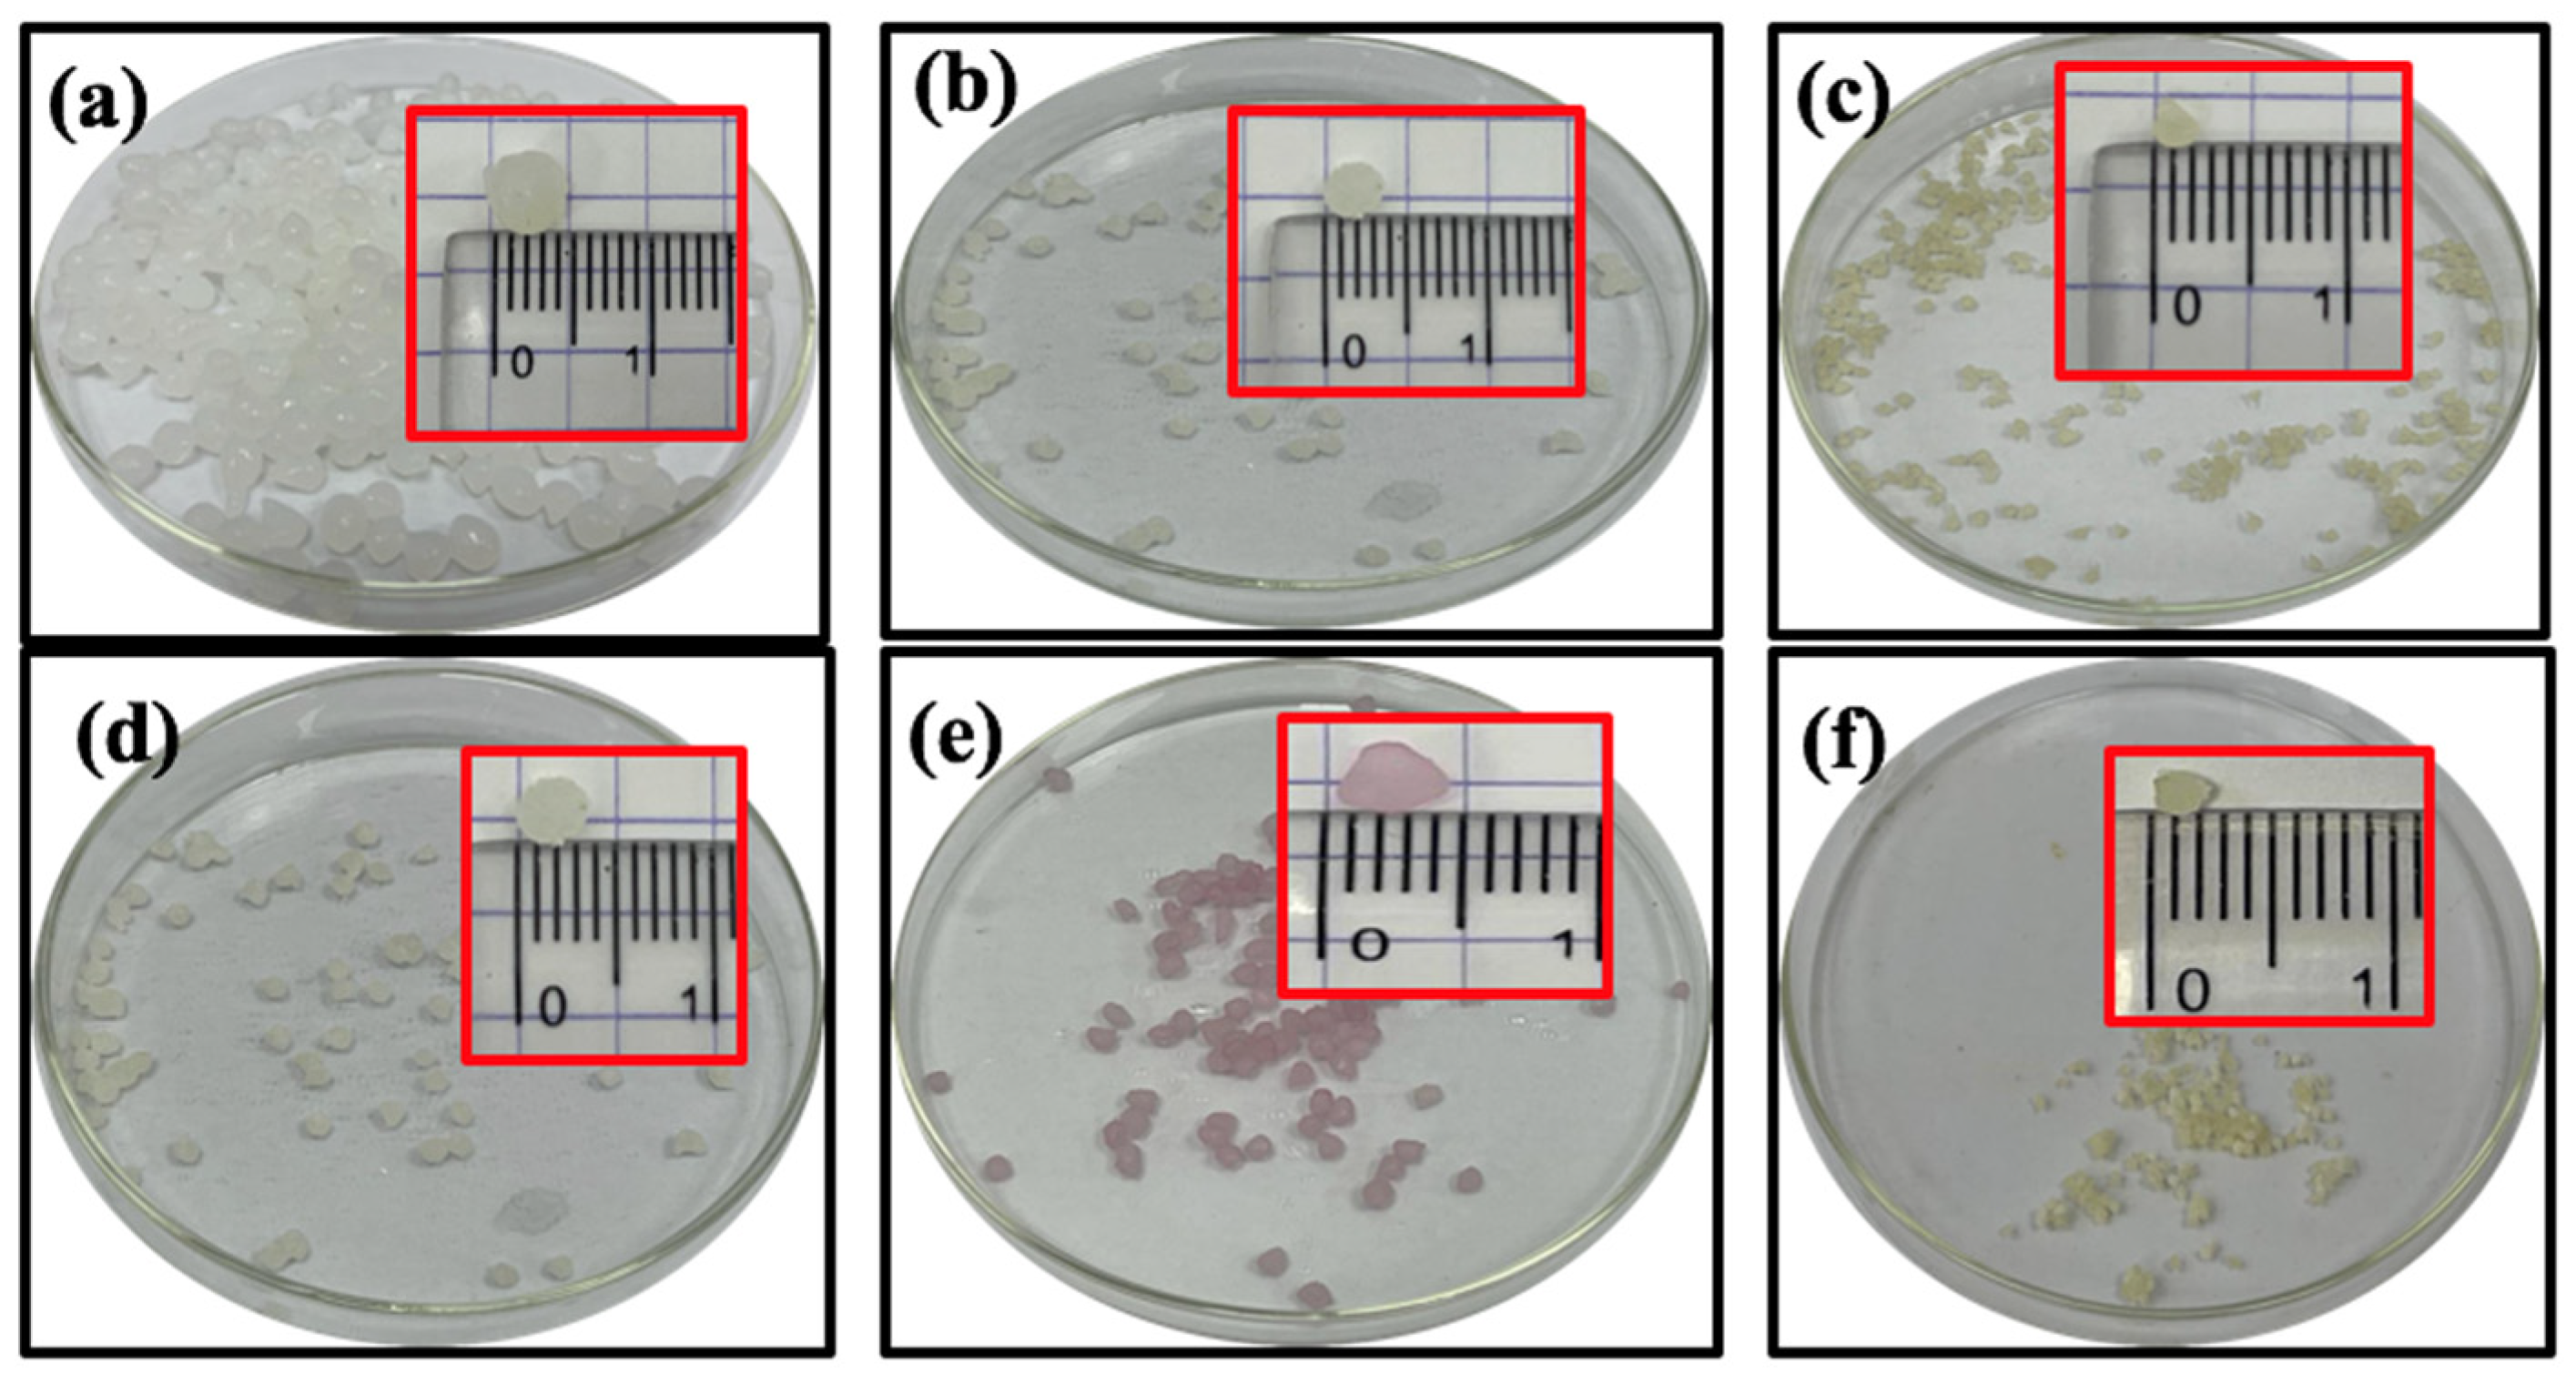
Gels 09 00328 g001

Synthesis and Characterization of Biodegradable Poly(vinyl alcohol)-Chitosan/Cellulose Hydrogel Beads for Efficient Removal of Pb(II), Cd(II), Zn(II), and Co(II) from Water
Abstract
1. Introduction
2. Results and Discussion
2.1. Design Rationale of Composite Hydrogel Beads
2.2. Structure and Chemical Composition
2.3. Morphology
2.4. Swelling Behavior
2.5. Adsorption Studies of Heavy Metals
2.5.1. Effect of pH on Metal Adsorption
2.5.2. Effect of Contact Time
2.5.3. Effect of the Initial Concentration of Heavy Metals
2.5.4. Effect of Adsorbent Dose
2.5.5. Effect of Temperature
2.5.6. Reusability of the Adsorbent
2.6. Adsorption Isotherms
2.7. Adsorption Kinetics
2.8. Adsorption Mechanism of Heavy Metal Ions
3. Conclusions
4. Experimental
4.1. Materials
4.2. Preparation of PVA-CS/CE Hydrogel Beads
4.3. Characterization of PVA-CS/CE Composite Hydrogels
4.4. Swelling Ratio Test
4.5. Adsorption of Heavy Metals
4.6. Adsorbent Reusability
4.7. Adsorption Isotherms
4.8. Adsorption Kinetics
4.9. Statistical Analysis
Author Contributions
Funding
Institutional Review Board Statement
Informed Consent Statement
Data Availability Statement
Conflicts of Interest
References
- Wang, D.; Cheng, W.; Yue, Y.; Xuan, L.; Ni, X.; Han, G. Electrospun cellulose nanocrystals/chitosan/polyvinyl alcohol nanofibrous films and their exploration to metal ions adsorption. Polymers 2018, 10, 1046. [Google Scholar] [CrossRef]
- Sanchez, L.M.; Shuttleworth, P.S.; Waiman, C.; Zanini, G.; Alvarez, V.A.; Ollier, R.P. Physically-crosslinked polyvinyl alcohol composite hydrogels containing clays, carbonaceous materials and magnetic nanoparticles as fillers. J. Environ. Chem. Eng. 2020, 8, 103795. [Google Scholar] [CrossRef]
- De Castro, M.L.F.A.; Abad, M.L.B.; Sumalinog, D.A.G.; Abarca, R.R.M.; Paoprasert, P.; de Luna, M.D.G. Adsorption of Methylene Blue dye and Cu(II) ions on EDTA-modified bentonite: Isotherm, kinetic and thermodynamic studies. Sustain. Environ. Res. 2018, 28, 197–205. [Google Scholar] [CrossRef]
- Akpor, O.B. Heavy Metal Pollutants in Wastewater Effluents: Sources, Effects and Remediation. Adv. Biosci. Bioeng. 2014, 2, 37. [Google Scholar] [CrossRef]
- Das, T.K.; Poater, A. Review on the use of heavy metal deposits from water treatment waste towards catalytic chemical syntheses. Int. J. Mol. Sci. 2021, 22, 13383. [Google Scholar] [CrossRef] [PubMed]
- Khan, F.S.A.; Mubarak, N.M.; Khalid, M.; Walvekar, R.; Abdullah, E.C.; Mazari, S.; Nizamuddin, S.; Karri, R.R. Magnetic nanoadsorbents’ potential route for heavy metals removal—A review. Environ. Sci. Pollut. Res. 2020, 27, 24342–24356. [Google Scholar] [CrossRef] [PubMed]
- Gupta, K.; Joshi, P.; Gusain, R.; Khatri, O.P. Recent advances in adsorptive removal of heavy metal and metalloid ions by metal oxide-based nanomaterials. Coord. Chem. Rev. 2021, 445, 214100. [Google Scholar] [CrossRef]
- Farooq, U.; Kozinski, J.A.; Khan, M.A.; Athar, M. Biosorption of heavy metal ions using wheat based biosorbents—A review of the recent literature. Bioresour. Technol. 2010, 101, 5043–5053. [Google Scholar] [CrossRef] [PubMed]
- Sonone, S.S.; Jadhav, S.; Sankhla, M.S.; Kumar, R. Water Contamination by Heavy Metals and their Toxic Effect on Aquaculture and Human Health through Food Chain. Lett. Appl. NanoBioScience 2020, 10, 2148–2166. [Google Scholar]
- Mu, R.; Liu, B.; Chen, X.; Wang, N.; Yang, J. Hydrogel adsorbent in industrial wastewater treatment and ecological environment protection. Environ. Technol. Innov. 2020, 20, 101107. [Google Scholar] [CrossRef]
- Xu, H.; Yuan, H.; Yu, J.; Lin, S. Study on the competitive adsorption and correlational mechanism for heavy metal ions using the carboxylated magnetic iron oxide nanoparticles (MNPs-COOH) as efficient adsorbents. Appl. Surf. Sci. 2019, 473, 960–966. [Google Scholar] [CrossRef]
- Jiang, C.; Wang, X.; Wang, G.; Hao, C.; Li, X.; Li, T. Adsorption performance of a polysaccharide composite hydrogel based on crosslinked glucan/chitosan for heavy metal ions. Compos. Part B Eng. 2019, 169, 45–54. [Google Scholar] [CrossRef]
- Son, D.-J.; Kim, W.-Y.; Jung, B.-R.; Chang, D.; Hong, K.-H. Pilot-scale anoxic/aerobic biofilter system combined with chemical precipitation for tertiary treatment of wastewater. J. Water Process. Eng. 2020, 35, 101224. [Google Scholar] [CrossRef]
- Yan, J.; Yuan, W.; Liu, J.; Ye, W.; Lin, J.; Xie, J.; Huang, X.; Gao, S.; Xie, J.; Liu, S.; et al. An integrated process of chemical precipitation and sulfate reduction for treatment of flue gas desulphurization wastewater from coal-fired power plant. J. Clean. Prod. 2019, 228, 63–72. [Google Scholar] [CrossRef]
- Zhang, X. Selective separation membranes for fractionating organics and salts for industrial wastewater treatment: Design strategies and process assessment. J. Membr. Sci. 2021, 643, 120052. [Google Scholar] [CrossRef]
- Moreira, V.R.; Lebron, Y.A.R.; Couto, C.F.; Maia, A.; Moravia, W.G.; Amaral, M.C.S. Process development for textile wastewater treatment towards zero liquid discharge: Integrating membrane separation process and advanced oxidation techniques. Process. Saf. Environ. Prot. 2021, 157, 537–546. [Google Scholar] [CrossRef]
- Zhao, C.; Zhou, J.; Yan, Y.; Yang, L.; Xing, G.; Li, H.; Wu, P.; Wang, M.; Zheng, H. Application of coagulation/flocculation in oily wastewater treatment: A review. Sci. Total. Environ. 2020, 765, 142795. [Google Scholar] [CrossRef] [PubMed]
- Wu, S.; Liu, Y.; Pan, Z.; Dai, P.; Yang, Q.; Lu, H. Treatment of electric desalting wastewater by swirling flotation coupled with medium coalescence. J. Environ. Chem. Eng. 2021, 9, 106055. [Google Scholar] [CrossRef]
- Rajoria, S.; Vashishtha, M.; Sangal, V.K. Review on the treatment of electroplating industry wastewater by electrochemical methods. Mater. Today Proc. 2021, 47, 1472–1479. [Google Scholar] [CrossRef]
- Akter, M.; Hirase, N.; Sikder, T.; Rahman, M.; Hosokawa, T.; Saito, T.; Kurasaki, M. Pb (II) Remediation from Aqueous Environment Using Chitosan-Activated Carbon-Polyvinyl Alcohol Composite Beads. Water Air Soil Pollut. 2021, 232, 272. [Google Scholar] [CrossRef]
- Aljar, M.A.A.; Rashdan, S.; El-Fattah, A.A. Environmentally Friendly Polyvinyl Alcohol Alginate/Bentonite Semi-Interpenetrating Polymer Network Nanocomposite Hydrogel Beads as An Efficient Adsorbent for the Removal of Methylene Blue from Aqueous Solution. Polymers 2021, 13, 4000. [Google Scholar] [CrossRef] [PubMed]
- Burakov, A.E.; Galunin, E.V.; Burakova, I.V.; Kucherova, A.E.; Agarwal, S.; Tkachev, A.G.; Gupta, V.K. Adsorption of heavy metals on conventional and nanostructured materials for wastewater treatment purposes: A review. Ecotoxicol. Environ. Saf. 2018, 148, 702–712. [Google Scholar] [CrossRef]
- Darban, Z.; Shahabuddin, S.; Gaur, R.; Ahmad, I.; Sridewi, N. Hydrogel-Based Adsorbent Material for the Effective Removal of Heavy Metals from Wastewater: A Comprehensive Review. Gels 2022, 8, 263. [Google Scholar] [CrossRef] [PubMed]
- Zulfiqar, M.; Lee, S.Y.; Mafize, A.A.; Kahar, N.A.M.A.; Johari, K.; Rabat, N.E. Efficient Removal of Pb(II) from Aqueous Solutions by Using Oil Palm Bio-Waste/MWCNTs Reinforced PVA Hydrogel Composites: Kinetic, Isotherm and Thermodynamic Modeling. Polymers 2020, 12, 430. [Google Scholar] [CrossRef] [PubMed]
- Jawad, A.H.; Norrahma, S.S.A.; Hameed, B.; Ismail, K. Chitosan-glyoxal film as a superior adsorbent for two structurally different reactive and acid dyes: Adsorption and mechanism study. Int. J. Biol. Macromol. 2019, 135, 569–581. [Google Scholar] [CrossRef] [PubMed]
- Jawad, A.H.; Islam, M.A.; Hameed, B.H. Cross-linked chitosan thin film coated onto glass plate as an effective adsorbent for adsorption of reactive orange 16. Int. J. Biol. Macromol. 2017, 95, 743–749. [Google Scholar] [CrossRef]
- El-Banna, F.S.; Mahfouz, M.E.; Leporatti, S.; El-Kemary, M.; Hanafy, N.A.N. Chitosan as a Natural Copolymer with Unique Properties for the Development of Hydrogels. Appl. Sci. 2019, 9, 2193. [Google Scholar] [CrossRef]
- Habiba, U.; Joo, T.C.; Siddique, T.A.; Salleh, A.; Ang, B.C.; Afifi, A.M. Effect of degree of deacetylation of chitosan on adsorption capacity and reusability of chitosan/polyvinyl alcohol/TiO2 nano composite. Int. J. Biol. Macromol. 2017, 104, 1133–1142. [Google Scholar] [CrossRef] [PubMed]
- Das, L.; Das, P.; Bhowal, A.; Bhattachariee, C. Synthesis of hybrid hydrogel nano-polymer composite using Graphene oxide, Chitosan and PVA and its application in waste water treatment. Environ. Technol. Innov. 2020, 18, 100664. [Google Scholar] [CrossRef]
- Majidnia, Z.; Fulazzaky, M.A. Photoreduction of Pb(II) ions from aqueous solution by titania polyvinylalcohol–alginate beads. J. Taiwan Inst. Chem. Eng. 2016, 66, 88–96. [Google Scholar] [CrossRef]
- Gomez-Maldonado, D.; Erramuspe, I.B.V.; Peresin, M.S. Natural polymers as alternative adsorbents and treatment agents for water remediation. Bioresources 2019, 14, 10093–10160. [Google Scholar] [CrossRef]
- Li, H.; Kruteva, M.; Dulle, M.; Wang, Z.; Mystek, K.; Ji, W.; Pettersson, T.; Wågberg, L. Understanding the Drying Behavior of Regenerated Cellulose Gel Beads: The Effects of Concentration and Nonsolvents. ACS Nano 2022, 16, 2608–2620. [Google Scholar] [CrossRef] [PubMed]
- Udoetok, I.A.; Wilson, L.D.; Headley, J.V. Self-Assembled and Cross-Linked Animal and Plant-Based Polysaccharides: Chitosan–Cellulose Composites and Their Anion Uptake Properties. ACS Appl. Mater. Interfaces 2016, 8, 33197–33209. [Google Scholar] [CrossRef] [PubMed]
- Chen, Y.; Li, J.; Lu, J.; Ding, M.; Chen, Y. Synthesis and properties of poly (vinyl alcohol) hydrogels with high strength and toughness. Polym. Test. 2022, 108, 107516. [Google Scholar] [CrossRef]
- Li, T.; Su, T.; Wang, J.; Zhu, S.; Zhang, Y.; Geng, Z.; Wang, X.; Gao, Y. Simultaneous removal of sulfate and nitrate from real high-salt flue gas wastewater concentrate via a waste heat crystallization route. J. Clean. Prod. 2023, 382, 135262. [Google Scholar] [CrossRef]
- Zhang, L.; Li, Y.; Guo, J.; Kan, Z.; Jia, Y. Catalytic ozonation mechanisms of Norfloxacin using Cu–CuFe2O4. Environ. Res. 2023, 216, 114521. [Google Scholar] [CrossRef] [PubMed]
- El-Fattah, A.A.; Mansour, A.Y.A. Viscoelasticity, mechanical properties, and in vitro biodegradation of injectable chitosan-poly(3-hydroxybutyrate-co-3-hydroxyvalerate)/nanohydroxyapatite composite hydrogel. Bull. Mater. Sci. 2018, 41, 1–10. [Google Scholar] [CrossRef]
- Jeevitha, D.; Amarnath, K. Chitosan/PLA nanoparticles as a novel carrier for the delivery of anthraquinone: Synthesis, characterization and in vitro cytotoxicity evaluation. Colloids Surfaces B Biointerfaces 2013, 101, 126–134. [Google Scholar] [CrossRef]
- Guo, Z.; Zhan, R.; Shi, Y.; Zhu, D.; Pan, J.; Yang, C.; Wang, Y.; Wang, J. Innovative and green utilization of zinc-bearing dust by hydrogen reduction: Recovery of zinc and lead, and synergetic preparation of Fe/C micro-electrolysis materials. Chem. Eng. J. 2023, 456, 141157. [Google Scholar] [CrossRef]
- Nisar, S.; Pandit, A.H.; Wang, L.-F.; Rattan, S. Strategy to design a smart photocleavable and pH sensitive chitosan based hydrogel through a novel crosslinker: A potential vehicle for controlled drug delivery. RSC Adv. 2020, 10, 14694–14704. [Google Scholar] [CrossRef] [PubMed]
- Demey, H.; Vincent, T.; Guibal, E. A novel algal-based sorbent for heavy metal removal. Chem. Eng. J. 2018, 332, 582–595. [Google Scholar] [CrossRef]
- Naseeruteen, F.; Hamid, N.S.A.; Suah, F.B.M.; Ngah, W.S.W.; Mehamod, F.S. Adsorption of malachite green from aqueous solution by using novel chitosan ionic liquid beads. Int. J. Biol. Macromol. 2018, 107, 1270–1277. [Google Scholar] [CrossRef] [PubMed]
- Esrafili, A.; Bagheri, S.; Kermani, M.; Gholami, M.; Moslemzadeh, M. Simultaneous adsorption of heavy metal ions (Cu2+ and Cd2+) from aqueous solutions by magnetic silica nanoparticles (Fe3O4@SiO2) modified using EDTA. Desalination Water Treat. 2019, 158, 207–215. [Google Scholar] [CrossRef]
- Sheth, Y.; Dharaskar, S.; Khalid, M.; Sonawane, S. An environment friendly approach for heavy metal removal from industrial wastewater using chitosan based biosorbent: A review. Sustain. Energy Technol. Assessments 2020, 43, 100951. [Google Scholar] [CrossRef]
- Bai, B.; Bai, F.; Li, X.; Nie, Q.; Jia, X.; Wu, H. The remediation efficiency of heavy metal pollutants in water by industrial red mud particle waste. Environ. Technol. Innov. 2022, 28, 102944. [Google Scholar] [CrossRef]
- Karim, M.R.; Aijaz, M.O.; Alharth, N.H.; Alharbi, H.F.; Al-Mubaddel, F.S.; Awual, M.R. Composite nanofibers membranes of poly (vinyl alcohol)/chitosan for selective lead (II) and cadmium (II) ions removal from wastewater. Ecotoxicol. Environ. Saf. 2019, 169, 479–486. [Google Scholar] [CrossRef] [PubMed]
- Bisiriyu, I.O.; Meijboom, R. Adsorption of Cu(II) ions from aqueous solution using pyridine-2,6-dicarboxylic acid crosslinked chitosan as a green biopolymer adsorbent. Int. J. Biol. Macromol. 2020, 165, 2484–2493. [Google Scholar] [CrossRef] [PubMed]
- Liu, Y.; Li, B.; Lei, X.; Liu, S.; Zhu, H.; Ding, E.; Ning, P. Novel method for high-performance simultaneous removal of NOx and SO2 by coupling yellow phosphorus emulsion with red mud. Chem. Eng. J. 2022, 428, 131991. [Google Scholar] [CrossRef]
- Guan, Q.; Zeng, G.; Song, J.; Liu, C.; Wang, Z.; Wu, S. Ultrasonic power combined with seed materials for recovery of phosphorus from swine wastewater via struvite crystallization process. J. Environ. Manage. 2021, 293, 112961. [Google Scholar] [CrossRef]
- Osińska, M. Removal of lead (II), copper (II), cobalt (II) and nickel (II) ions from aqueous solutions using carbon gels. J. Solgel. Sci. Technol. 2017, 81, 678–692. [Google Scholar] [CrossRef]
- Dharmapriya, T.N.; Li, D.; Chung, Y.C.; Huang, P.J. Green synthesis of reusable adsorbents for the removal of heavy metal ions. ACS Omega 2021, 6, 30478–30487. [Google Scholar] [CrossRef] [PubMed]
- Zhou, Y.; Zhang, L.; Fu, S.; Zheng, L.; Zhan, H. Adsorption Behavior of Cd2+, Pb2+, and Ni2+ from Aqueous Solutions on Cellulose-Based Hydrogels. Bioresources 2012, 7, 2752–2765. [Google Scholar]
- Kubilay, Ş.; Gürkan, R.; Savran, A.; Şahan, T. Removal of Cu (II), Zn (II) and Co (II) ions from aqueous solutions by adsorption onto natural bentonite. Adsorption 2007, 13, 41–51. [Google Scholar] [CrossRef]
- Nadaroglu, H.; Kalkan, E. Removal of cobalt (II) ions from aqueous solution by using alternative adsorbent industrial red mud waste material. Int. J. Phys. Sci. 2012, 7, 1386–1394. [Google Scholar]
- Ahmad, R.; Mirza, A. Facile one pot green synthesis of Chitosan-Iron oxide (CS-Fe2O3) nanocomposite: Removal of Pb(II) and Cd(II) from synthetic and industrial wastewater. J. Clean. Prod. 2018, 186, 342–352. [Google Scholar] [CrossRef]
- Dandil, S.; Sahbaz, D.A.; Acikgoz, C. Adsorption of Cu (II) ions onto crosslinked chitosan/Waste Active Sludge Char (WASC) beads: Kinetic, equilibrium, and thermodynamic study. Int. J. Biol. Macromol. 2019, 136, 668–675. [Google Scholar] [CrossRef] [PubMed]
- Mu, R.; Liu, B.; Chen, X.; Wang, N.; Yang, J. Adsorption of Cu(II) and Co(II) from aqueous solution using lignosulfonate/chitosan adsorbent. Int. J. Biol. Macromol. 2020, 163, 120–127. [Google Scholar] [CrossRef] [PubMed]
- Zhang, X.; Ma, F.; Dai, Z.; Wang, J.; Chen, L.; Ling, H.; Soltanian, M.R. Radionuclide transport in multi-scale fractured rocks: A review. J. Hazard. Mater. 2022, 424, 127550. [Google Scholar] [CrossRef]
- Aslani, H.; Ebrahimi Kosari, T.; Naseri, S.; Nabizadeh, R.; Khazaei, M. Hexavalent chromium removal from aqueous solution using functionalized chitosan as a novel nano-adsorbent: Modeling and optimization, kinetic, isotherm, and thermodynamic studies, and toxicity testing. Environ. Sci. Pollut. Res. 2018, 25, 20154–20168. [Google Scholar] [CrossRef]
- Fan, J.P.; Luo, J.J.; Zhang, X.H.; Zhen, B.; Dong, C.Y.; Li, Y.C.; Shen, J.; Yu-Tong Cheng, Y.T.; Chen, H.P. A novel electrospun β-CD/CS/PVA nanofiber membrane for simultaneous and rapid removal of organic micropollutants and heavy metal ions from water. J. Chem. Eng. 2019, 378, 122232. [Google Scholar] [CrossRef]
- Sun, X.; Peng, B.; Ji, Y.; Chen, J.; Li, D. Chitosan (chitin)/cellulose composite biosorbents prepared using ionic liquid for heavy metal ions adsorption. AIChE J. 2009, 55, 2062–2069. [Google Scholar] [CrossRef]
- Chethan, P.D.; Vishalakshi, B. Synthesis of ethylenediamine modified chitosan and evaluation for removal of divalent metal ions. Carbohydr. Polym. 2013, 97, 530–536. [Google Scholar] [CrossRef]
- Tassanapukdee, Y.; Prayongpan, P.; Songsrirote, K. Removal of heavy metal ions from an aqueous solution by CS/PVA/PVP composite hydrogel synthesized using microwaved-assisted irradiation. Environ. Technol. Innov. 2021, 24, 101898. [Google Scholar] [CrossRef]
- Yu, Z.; Dang, Q.; Liu, C.; Cha, D.; Zhang, H.; Zhu, W.; Zhang, Q.; Fan, B. Preparation and characterization of poly (maleic acid)-grafted cross-linked chitosan microspheres for Cd(II) adsorption. Carbohydr. Polym. 2017, 172, 28–39. [Google Scholar] [CrossRef]
- Zhang, G.; Qu, R.; Sun, C.; Ji, C.; Chen, H.; Wang, C.; Niu, Y. Adsorption for metal ions of chitosan coated cotton fiber. J. Appl. Polym. Sci. 2008, 110, 2321–2327. [Google Scholar] [CrossRef]
- Zhu, Y.; Hu, J.; Wang, J. Competitive adsorption of Pb(II), Cu(II) and Zn(II) onto xanthate-modified magnetic chitosan. J. Hazard. Mater. 2012, 221, 155–161. [Google Scholar] [CrossRef]
- Zhu, Y.; Hu, J.; Wang, J. Removal of Co2+ from radioactive wastewater by polyvinyl alcohol (PVA)/chitosan magnetic composite. Prog. Nucl. Energy 2014, 71, 172–178. [Google Scholar] [CrossRef]
- Ma, F.; Zhu, W.; Cheng, W.; Chen, J.; Gao, J.; Xue, Y.; Yan, Y. Removal of cobalt ions (II) from simulated radioactive effluent by electrosorption on potassium hydroxide modified activated carbon fiber felt. J. Water Process. Eng. 2023, 53, 103635. [Google Scholar] [CrossRef]
- Esmaeili, A.; Beni, A.A. A novel fixed-bed reactor design incorporating an electrospun PVA/chitosan nanofiber membrane. J. Hazard. Mater. 2014, 280, 788–796. [Google Scholar] [CrossRef] [PubMed]
- Ahmed, A.; Ayad, M.I.; Eledkawy, M.A.; Darweesh, M.; Elmelegy, E.M. Removal of iron, zinc, and nickel-ions using nano bentonite and its applications on power station wastewater. Heliyon 2021, 7, e06315. [Google Scholar] [CrossRef]
- Sun, Y.; Liu, X.; Lv, X.; Wang, T.; Xue, B. Synthesis of novel lignosulfonate-modified graphene hydrogel for ultrahigh adsorption capacity of Cr (VI) from wastewater. J. Clean. Prod. 2021, 295, 126406. [Google Scholar] [CrossRef]
- Weijiang, Z.; Yace, Z.; Yuvaraja, G.; Jiao, X. Adsorption of Pb(II) ions from aqueous environment using eco-friendly chitosan schiff’s base@Fe3O4 (CSB@Fe3O4) as an adsorbent; kinetics, isotherm and thermodynamic studies. Int. J. Biol. Macromol. 2017, 105, 422–430. [Google Scholar] [CrossRef] [PubMed]
- Bai, B.; Bai, F.; Sun, C.; Nie, Q.; Sun, S. Adsorption mechanism of shell powders on heavy metal ions Pb2+/Cd2+ and the purification efficiency for contaminated soils. Front. Earth Sci. 2023, 10, 1071228. [Google Scholar] [CrossRef]

| Model | Parameter | Pb(II) | Cd(II) | Zn(II) | Co(II) |
|---|---|---|---|---|---|
| Langmuir equation | qm (mg/g) | 50.54 | 41.82 | 26.74 | 20.53 |
| RL | 0.054–0.187 | 0.029–0.109 | 0.015–0.014 | 0.043–0.141 | |
| R2 | 0.993 | 0.968 | 0.996 | 0.994 | |
| KL | 0.087 | 0.163 | 1.422 | 0.121 | |
| Freundlich equation | KF (L/mg) | 5.26 | 4.34 | 9.22 | 4.67 |
| 1/n | 0.688 | 0.438 | 0.407 | 0.753 | |
| R2 | 0.979 | 0.999 | 0.993 | 0.997 |
| Model | Parameter | Pb(II) | Cd(II) | Zn(II) | Co(II) |
|---|---|---|---|---|---|
| Pseudo-first order | R2 | 0.8434 | 0.9098 | 0.5026 | 0.9031 |
| qe (mg/g) | 0.4045 | 0.1476 | 0.5277 | 0.8332 | |
| K1 (min−1) | 0.0353 | 0.0173 | 0.0584 | 0.0136 | |
| Pseudo-second order | R2 | 0.9996 | 1.00 | 1.00 | 0.9974 |
| qe (mg/g) | 4.9671 | 4.9531 | 4.0566 | 4.2694 | |
| K2 (g/mg.min) | 0.0953 | 0.2748 | 0.1625 | 0.0343 | |
| qe (experimental) | 4.9321 | 4.9423 | 4.9901 | 4.1561 |
| Metal | Adsorbent | Adsorption Capacity (mg/g) | Reference |
|---|---|---|---|
| Pb(II) | Chitosan/polyvinyl alcohol/β-cyclodextrin membrane | 13.44 | [60] |
| Chitosan/activated carbon/polyvinyl alcohol composite | 22.47 | [20] | |
| Chitosan/cellulose composite | 26.81 | [61] | |
| Ethylenediamine modified chitosan | 30.57 | [62] | |
| PVA-CS/CE composite hydrogel beads | 50.54 | This study | |
| Cd(II) | Chitosan/polyvinyl alcohol/polyvinylpyrrolidone hydrogel | 08.36 | [63] |
| Poly(maleic acid)-grafted crosslinked chitosan microspheres | 39.21 | [64] | |
| Chitosan-coated cotton fibers | 15.74 | [65] | |
| PVA-CS/CE composite hydrogel beads | 41.82 | This study | |
| Zn(II) | Chitosan/cellulose composite | 19.81 | [61] |
| Xanthate-modified magnetic chitosan composite | 20.8 | [66] | |
| Ethylenediamine modified chitosan | 19.4 | [62] | |
| PVA-CS/CE composite hydrogel beads | 26.74 | This study | |
| Co(II) | Chitosan/poly(vinyl alcohol) magnetic composite | 14.39 | [67] |
| Potassium hydroxide-modified activated carbon fiber | 14.80 | [68] | |
| Poly(vinyl alcohol)/chitosan nanofiber membrane | 17.80 | [69] | |
| PVA-CS/CE composite hydrogel beads | 20.53 | This study |
Disclaimer/Publisher’s Note: The statements, opinions and data contained in all publications are solely those of the individual author(s) and contributor(s) and not of MDPI and/or the editor(s). MDPI and/or the editor(s) disclaim responsibility for any injury to people or property resulting from any ideas, methods, instructions or products referred to in the content. |
© 2023 by the authors. Licensee MDPI, Basel, Switzerland. This article is an open access article distributed under the terms and conditions of the Creative Commons Attribution (CC BY) license (https://creativecommons.org/licenses/by/4.0/).
Share and Cite
Aljar, M.A.A.; Rashdan, S.; Almutawah, A.; El-Fattah, A.A. Synthesis and Characterization of Biodegradable Poly(vinyl alcohol)-Chitosan/Cellulose Hydrogel Beads for Efficient Removal of Pb(II), Cd(II), Zn(II), and Co(II) from Water. Gels 2023, 9, 328. https://doi.org/10.3390/gels9040328
Aljar MAA, Rashdan S, Almutawah A, El-Fattah AA. Synthesis and Characterization of Biodegradable Poly(vinyl alcohol)-Chitosan/Cellulose Hydrogel Beads for Efficient Removal of Pb(II), Cd(II), Zn(II), and Co(II) from Water. Gels. 2023; 9(4):328. https://doi.org/10.3390/gels9040328
Chicago/Turabian StyleAljar, Mona A. Aziz, Suad Rashdan, Abdulla Almutawah, and Ahmed Abd El-Fattah. 2023. "Synthesis and Characterization of Biodegradable Poly(vinyl alcohol)-Chitosan/Cellulose Hydrogel Beads for Efficient Removal of Pb(II), Cd(II), Zn(II), and Co(II) from Water" Gels 9, no. 4: 328. https://doi.org/10.3390/gels9040328
APA StyleAljar, M. A. A., Rashdan, S., Almutawah, A., & El-Fattah, A. A. (2023). Synthesis and Characterization of Biodegradable Poly(vinyl alcohol)-Chitosan/Cellulose Hydrogel Beads for Efficient Removal of Pb(II), Cd(II), Zn(II), and Co(II) from Water. Gels, 9(4), 328. https://doi.org/10.3390/gels9040328

